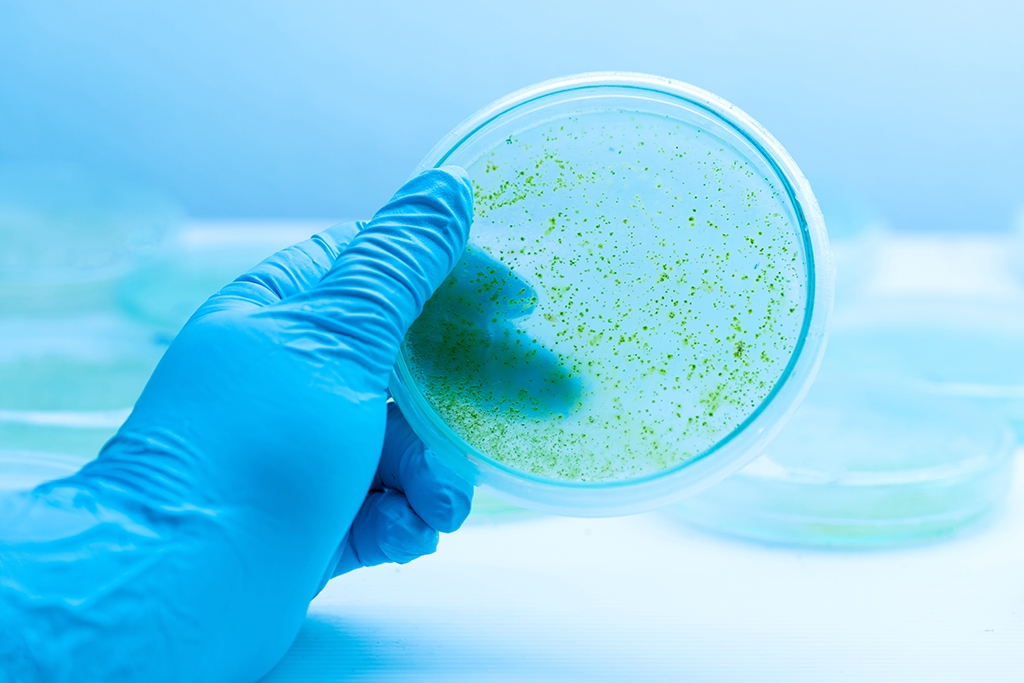

Cyanobacterium re-engineered to produce 1-butanol from CO2
Researchers from Uppsala University have successfully re-engineered Cyanobacterium Synechocystis PCC 6803 to effectively produce 1-butanol and other chemicals from water and CO2.
Cyanobacteria can be engineered to directly convert CO2 and water into biofuel and chemicals through photosynthesis. The efficiency and speed of the synthesis is still too low for industrial use, however.
In the study, led by Peter Lindblad (SciLifeLab/UU), researchers modified the cyanobacterium Synechocystis PCC 6803, enabling efficient biosynthesis of 1-butanol, a chemical that could substitute gasoline.
The researchers managed to produce the highest 1-butanol production from CO2 reported so far and the new strategy represents a blue-print for a variety of future synthesis in photosynthetic microorganisms.
The study was published in the journal Energy & Environmental Science